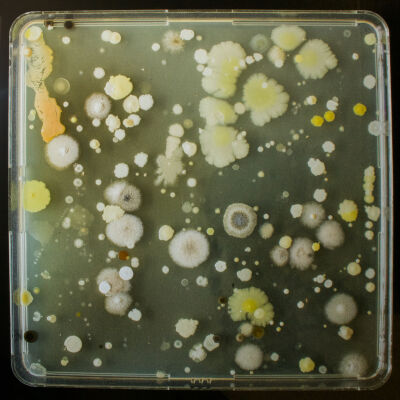
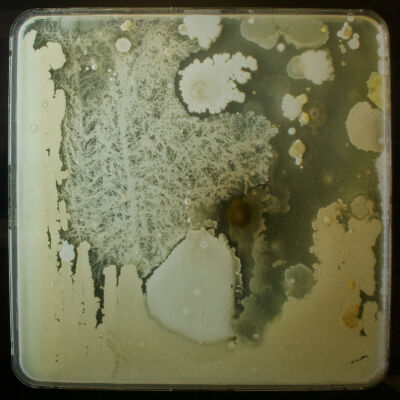

Medcan Art Collection - All Entries
 "Fishing in the Summer" 186-0170
"Fishing in the Summer" 186-0170 #119 afternoon studio floor
#119 afternoon studio floor 072-2747
072-2747 5 Colour Process- Looking Down
5 Colour Process- Looking Down A Friend in the Yard
A Friend in the Yard A Gallon
A Gallon A Gallon (Red)
A Gallon (Red) A Hockey Rink that Siassie, Bob , Fred, Tuktu Made
A Hockey Rink that Siassie, Bob , Fred, Tuktu Made A Map of the Stars (The North Pole)
A Map of the Stars (The North Pole) A Map of the Stars (The South Pole)
A Map of the Stars (The South Pole) A New Born
A New Born A Piece of Glass/ Sideglances/ Glad I Remembered to Smile
A Piece of Glass/ Sideglances/ Glad I Remembered to Smile A Time Capsule, A True Abode 1
A Time Capsule, A True Abode 1 A to Zzzz
A to Zzzz AR-Wave #86
AR-Wave #86 Aerial View of Camp
Aerial View of Camp Agape/ Agape
Agape/ Agape All Signs Point Away from Center
All Signs Point Away from Center An Arborist
An Arborist Apologue II: The Birds of Paradise
Apologue II: The Birds of Paradise Approval by the Comics Code Authority
Approval by the Comics Code Authority Aqiattulaulavik
Aqiattulaulavik Arm and Yellow Disc
Arm and Yellow Disc Art Deco Taotie
Art Deco Taotie Arthur’s House
Arthur’s House Ascension
Ascension Astral Plane
Astral Plane At the Cabin
At the Cabin Barcodes
Barcodes Basket #5
Basket #5 Basket #8
Basket #8 Beaded Amauti
Beaded Amauti Bee
Bee Bee (Blue Black)
Bee (Blue Black) Bee (Orange Cream Double Kiss)
Bee (Orange Cream Double Kiss) Bee (Yellow Lavender Gloss)
Bee (Yellow Lavender Gloss) Bent Lines
Bent Lines Between '17 and '18
Between '17 and '18 Between '17 and '18
Between '17 and '18 Blue Movement
Blue Movement Bokeh Mirror (Full length)
Bokeh Mirror (Full length) Bouquet (small colour 1)
Bouquet (small colour 1) Bouquet for Acapulco
Bouquet for Acapulco Breathe
Breathe Broken Ceramics and Wood on Blue (Abundance, Archaeology, Desire, Distribution, Economy, Excess, Failure, Frustration, History, Isolation, Longevity, Luxury, Memory, Precarity, Production, Success, Uncertainty)
Broken Ceramics and Wood on Blue (Abundance, Archaeology, Desire, Distribution, Economy, Excess, Failure, Frustration, History, Isolation, Longevity, Luxury, Memory, Precarity, Production, Success, Uncertainty) Buddha Taking a Selfie
Buddha Taking a Selfie Butler's Pantry
Butler's Pantry Casual system
Casual system Cells and Tissues
Cells and Tissues Ceramic Bowl with Papaya and Clementines on Blue with Middle Grey (Abundance, Anxiety, Balance, Citrus Collapes, Digestion, Distribution, History, Isolation, Meditation, Precarity, Saturation, Storage, Uncertainty)
Ceramic Bowl with Papaya and Clementines on Blue with Middle Grey (Abundance, Anxiety, Balance, Citrus Collapes, Digestion, Distribution, History, Isolation, Meditation, Precarity, Saturation, Storage, Uncertainty) Cheek by Jowl (Constellation 1)
Cheek by Jowl (Constellation 1) Chiromancie #12 Goma No. 2
Chiromancie #12 Goma No. 2 Chiromancie #14 n°9
Chiromancie #14 n°9 Clear Eyes Full Heart
Clear Eyes Full Heart Cobblestone Garden #1 (After Arthur Erickson)
Cobblestone Garden #1 (After Arthur Erickson) Cobblestone Garden #4 (After Arthur Erickson)
Cobblestone Garden #4 (After Arthur Erickson) Composition
Composition Composition (Building A House)
Composition (Building A House) Composition (Coloured Pencils)
Composition (Coloured Pencils) Composition (Kinngait Hotel)
Composition (Kinngait Hotel) Composition (Quilt Pattern)
Composition (Quilt Pattern) Composition (Shipper Skippers)
Composition (Shipper Skippers) Composition 2: Mother of Salt Water
Composition 2: Mother of Salt Water Composition 2: Waiting Inside a Rock
Composition 2: Waiting Inside a Rock Convalescent Swallow
Convalescent Swallow Coulis
Coulis Cross
Cross Crossed Guitars
Crossed Guitars Crusher (Rust)
Crusher (Rust) Crusher (Yellow Ochre)
Crusher (Yellow Ochre) DS
DS Daisy
Daisy Done Deal
Done Deal Double Fake Double Morisseau
Double Fake Double Morisseau Drawing on the Floor
Drawing on the Floor Droplets Lemon Sprout
Droplets Lemon Sprout Dryland Farming #24, Monegros County, Aragon, Spain 2010
Dryland Farming #24, Monegros County, Aragon, Spain 2010 Du Printemps
Du Printemps Dublin 1
Dublin 1 Einstein
Einstein Elegy for Alex Wildstar
Elegy for Alex Wildstar Elizabeth the Second, The Gazette Tuesday, June 2, 1953
Elizabeth the Second, The Gazette Tuesday, June 2, 1953 Embrasure
Embrasure Embroidered Monochrome Propositions: O series
Embroidered Monochrome Propositions: O series Embroidered Monochrome Propositions: O series
Embroidered Monochrome Propositions: O series Emergency in Waiting (Gold)
Emergency in Waiting (Gold) En Text 1-5 (should-change-old-pre-end)
En Text 1-5 (should-change-old-pre-end) Endless Spring VII
Endless Spring VII Entrevoir le jour _ Horizon 7
Entrevoir le jour _ Horizon 7 Escape to Paradise
Escape to Paradise Eye-beam
Eye-beam Farnsworth Sampler
Farnsworth Sampler Faux Monuments Object #3
Faux Monuments Object #3 Fill
Fill First Flight
First Flight Flottes 9
Flottes 9 Flowers
Flowers Flowers #2 (Changing Whites)
Flowers #2 (Changing Whites) Flowers #2 (Lavender Yellow Gloss)
Flowers #2 (Lavender Yellow Gloss) Flowers #2 (Orange Cream)
Flowers #2 (Orange Cream) Flowers (double kiss)
Flowers (double kiss) Flowers (peach and green)
Flowers (peach and green) Forever in the Sky (Mission, San Francisco)
Forever in the Sky (Mission, San Francisco) Frame #2 (Med)
Frame #2 (Med) Framing Potential
Framing Potential Frost
Frost GTO Racer X I Love My Car Go-Boy
GTO Racer X I Love My Car Go-Boy Ghost Fragment B52 (Freer Study Collection)
Ghost Fragment B52 (Freer Study Collection) Gloucester Composite
Gloucester Composite Gut Jacket II
Gut Jacket II Gut Jacket III
Gut Jacket III Géométrie variable, 6-1
Géométrie variable, 6-1 Géométrie variable, 6-2
Géométrie variable, 6-2 Hanging by a thread. Numero 6
Hanging by a thread. Numero 6 Hautes herbes
Hautes herbes Hose with Yellow Stand on Burnt Sienna (Ambiguity, Archaeology, Balance, Culture, Digital, Economy, Modern, Production, Translation, Unnecessary)
Hose with Yellow Stand on Burnt Sienna (Ambiguity, Archaeology, Balance, Culture, Digital, Economy, Modern, Production, Translation, Unnecessary) Hot House
Hot House House with Scaffolding, Seyðisfjörður
House with Scaffolding, Seyðisfjörður House, Seyðisfjörður
House, Seyðisfjörður Hurry Hard
Hurry Hard I Like!
I Like! I Reinforced with such determined frequency that I would dissonate
I Reinforced with such determined frequency that I would dissonate In Absentia (Ultramarine Blue - White)
In Absentia (Ultramarine Blue - White) In Search of Beluga
In Search of Beluga Inside the Mountain
Inside the Mountain Inside the Mountain
Inside the Mountain Intercom
Intercom Inuvik's Fox Tail Flowers
Inuvik's Fox Tail Flowers Jasper, Elizabeth, Wilfrid, Zeiss, William
Jasper, Elizabeth, Wilfrid, Zeiss, William K-PG
K-PG Kimono Target: Omotesando
Kimono Target: Omotesando La Guardia
La Guardia Ladies in Beaded Amautiq
Ladies in Beaded Amautiq Laptop with Ukulele
Laptop with Ukulele Laundry
Laundry Le Buckminsterfullerene!
Le Buckminsterfullerene! Les belle surprises
Les belle surprises Les couleurs de Cezanne dans les mots des Rilke 4/ 100-Essai
Les couleurs de Cezanne dans les mots des Rilke 4/ 100-Essai Lisa lives on that Island
Lisa lives on that Island Lombardo House
Lombardo House Lonely Couple
Lonely Couple Magnetic Separation (Graphite)
Magnetic Separation (Graphite) Mamie Till
Mamie Till Maritime
Maritime Mass
Mass Meditation
Meditation Menzel's Foot
Menzel's Foot Mesoderm (Yellow Sprouts)
Mesoderm (Yellow Sprouts) Microbes Swabbed from a Pallet Used by A.J. Casson
Microbes Swabbed from a Pallet Used by A.J. Casson Microbes Swabbed from a Pallet Used by Frederick Varley
Microbes Swabbed from a Pallet Used by Frederick Varley Microbes Swabbed from a Pallet Used by Tom Thomson
Microbes Swabbed from a Pallet Used by Tom Thomson Mirror (Paris) #2
Mirror (Paris) #2 Moi au Louvre
Moi au Louvre Mon Hiver Chez Toi
Mon Hiver Chez Toi Mother
Mother Mountain Grove Gathering
Mountain Grove Gathering Mountainside
Mountainside Mountainside
Mountainside Mud Wrestle
Mud Wrestle Multicolour Crochet
Multicolour Crochet Munari's Eyes
Munari's Eyes My Dream Gold Pin
My Dream Gold Pin My Trip to Europe
My Trip to Europe New Line of Gravity #4
New Line of Gravity #4 New Line of Gravity #5
New Line of Gravity #5 New Line of Gravity #6
New Line of Gravity #6 New Line of Gravity #7
New Line of Gravity #7 Night Eye
Night Eye No. 20
No. 20 Nope
Nope Northern River 5 Camera Crane
Northern River 5 Camera Crane Nourish
Nourish Oasis
Oasis Oil Bunkering #2, Niger Delta, Nigeria, 2016
Oil Bunkering #2, Niger Delta, Nigeria, 2016 On the Warpath: Issue #7
On the Warpath: Issue #7 One Line has Two Shapes- No.1
One Line has Two Shapes- No.1 One Line has Two Shapes- No.2
One Line has Two Shapes- No.2 One Time or Another
One Time or Another Opera
Opera Orange Acoustic
Orange Acoustic Orbits (zen)
Orbits (zen) Osyter Catcher
Osyter Catcher Par dessus/ dessous #9
Par dessus/ dessous #9 Paradise
Paradise Pick Cherry
Pick Cherry Picture 5, Toronto (Panel 1)
Picture 5, Toronto (Panel 1) Picture 5, Toronto (Panel 2)
Picture 5, Toronto (Panel 2) Pink Coat and Rhododendrons
Pink Coat and Rhododendrons Portrait of Malaika I
Portrait of Malaika I Pretty Machine 2
Pretty Machine 2 Raisin River
Raisin River Rationalizing Solitary Efforts to Substantiate Fiction
Rationalizing Solitary Efforts to Substantiate Fiction Rebirth of Chill
Rebirth of Chill Red Clover (Trifolium) Blue
Red Clover (Trifolium) Blue Red Foxgloves with Thorns (Neoliberalism)
Red Foxgloves with Thorns (Neoliberalism) Rework
Rework Ritualized Comfort without Historical Authority
Ritualized Comfort without Historical Authority Rudy the Rabbit
Rudy the Rabbit Rudy the Rabbit (Orange and Teal)
Rudy the Rabbit (Orange and Teal) Rudy the Rabbit (Red and Blue)
Rudy the Rabbit (Red and Blue) Rustic Hero
Rustic Hero Salt Ponds #4, Near Naglou Sam Sam, Senegal, 2019
Salt Ponds #4, Near Naglou Sam Sam, Senegal, 2019 San Titre (Spencer Finch)
San Titre (Spencer Finch) San Titre (flux 2019.02.23)
San Titre (flux 2019.02.23) San Titre (flux 2019.05.21)
San Titre (flux 2019.05.21) Sarrasine (Balzac)
Sarrasine (Balzac) Sea wall
Sea wall Seeing Studies: Trellis
Seeing Studies: Trellis Self-Portrait with Lemon Heart
Self-Portrait with Lemon Heart Semiotics Aside (Landscape 020)
Semiotics Aside (Landscape 020) Seraph
Seraph Shila the Great
Shila the Great Silent Trans-Forming
Silent Trans-Forming Single Mother of Three Boys
Single Mother of Three Boys Sketch 2 (stairwell)
Sketch 2 (stairwell) Slave Lake
Slave Lake Snowblob #1
Snowblob #1 Soie verte
Soie verte Solid Plans (Petrified Wood)
Solid Plans (Petrified Wood) Spine
Spine Star Value Maps
Star Value Maps Storage
Storage Strawberry Letter
Strawberry Letter Structural Trap (Salt)
Structural Trap (Salt) Studio Portrait (Man Playing Chess)
Studio Portrait (Man Playing Chess) Study for a Landscape #1, #2, #3, #4, #5, #6, #7, #8
Study for a Landscape #1, #2, #3, #4, #5, #6, #7, #8 Study of Two Fish
Study of Two Fish Sunset Worm I
Sunset Worm I Sunset Worm II
Sunset Worm II Sword of the Sun
Sword of the Sun Synapse (38-01)
Synapse (38-01) Takeout (Coffee)
Takeout (Coffee) Tattooed Faces
Tattooed Faces Terra Portfiolio D
Terra Portfiolio D Terra Portfolio A
Terra Portfolio A Terra Portfolio B
Terra Portfolio B Terra Portfolio C
Terra Portfolio C Terra Portfolio E
Terra Portfolio E The Archer 11
The Archer 11 The Bend
The Bend The Club
The Club The Difference Between
The Difference Between The Fabric. The Anger. The River. 02
The Fabric. The Anger. The River. 02 The Guy with the Eyes
The Guy with the Eyes The Park (Pale Peach)
The Park (Pale Peach) The Park (Yellow Lavender Gloss)
The Park (Yellow Lavender Gloss) The Place I would like to be with you
The Place I would like to be with you The Senses, for Colour Blindness
The Senses, for Colour Blindness The Sound of a Rainbow, Colour Ripple
The Sound of a Rainbow, Colour Ripple The Threads that Connect Us
The Threads that Connect Us The Three
The Three The Three Sisters
The Three Sisters The Tower
The Tower Thirteen Pouches for Thirteen Songs
Thirteen Pouches for Thirteen Songs Three Inuit are camping near the East side of Baker Lake to camp for the summer in July
Three Inuit are camping near the East side of Baker Lake to camp for the summer in July Threshhold, 11 Ossington Avenue
Threshhold, 11 Ossington Avenue Threshold, 11 Garnet Avenue
Threshold, 11 Garnet Avenue Threshold, 2 Concord Avenue
Threshold, 2 Concord Avenue Tidal Structure
Tidal Structure Token (Monkey Jar)
Token (Monkey Jar) Tree ( Lavender Yellow)
Tree ( Lavender Yellow) Tree (Lavender Cream)
Tree (Lavender Cream) Tree (Lavender Pale Blue)
Tree (Lavender Pale Blue) Tree (Lavender Pink)
Tree (Lavender Pink) Tree (Yellow Lavender Double Kiss)
Tree (Yellow Lavender Double Kiss) Tree (green and pink)
Tree (green and pink) Tree (peach and green)
Tree (peach and green) Trellis
Trellis Trembling Lake
Trembling Lake Two Inuit are walking Through The Mountains and one are carrying caribou on there back in June
Two Inuit are walking Through The Mountains and one are carrying caribou on there back in June Two Quinnquliks
Two Quinnquliks Two Reds and a Blue
Two Reds and a Blue Uncategory 14 Land
Uncategory 14 Land Unfurling Limb
Unfurling Limb Untitiled 05
Untitiled 05 Untitled
Untitled Untitled
Untitled Untitled
Untitled Untitled
Untitled Untitled
Untitled Untitled
Untitled Untitled
Untitled Untitled
Untitled Untitled
Untitled Untitled (Black and White #2)
Untitled (Black and White #2) Untitled (Blancs D'Ombres i)
Untitled (Blancs D'Ombres i) Untitled (Sanderling)
Untitled (Sanderling) Untitled (Spring Breakup)
Untitled (Spring Breakup) Untitled (Vine of Globes)
Untitled (Vine of Globes) Untitled (composition)
Untitled (composition) Untitled (tent)
Untitled (tent) Untitled (tent)
Untitled (tent) Untltled (composition)
Untltled (composition) Utopia #2
Utopia #2 Waabigwan Composition (study)
Waabigwan Composition (study) Water Rises Above (Anìwibi)
Water Rises Above (Anìwibi) Watermelon
Watermelon We Root Up with the Stars
We Root Up with the Stars Whale Hunting
Whale Hunting Whalebone Compostion I
Whalebone Compostion I Whalebone Compostion II
Whalebone Compostion II White Castle
White Castle Winter Flower
Winter Flower Winter Sleight Ride (Maud Lewis/ Canada Post)
Winter Sleight Ride (Maud Lewis/ Canada Post) Winterlude
Winterlude Wood 1
Wood 1 Wood 3
Wood 3 Wrapped
Wrapped Wrapped Monochrome
Wrapped Monochrome Yes, OK, Soul Power
Yes, OK, Soul Power You Be Me
You Be Me Zusatzblatt
Zusatzblatt press++30.47
press++30.47 untitled (emerging figure)
untitled (emerging figure) you can be someone if you crawl with me (1)
you can be someone if you crawl with me (1) you can be someone if you crawl with me (2)
you can be someone if you crawl with me (2) you can be someone if you crawl with me (3)
you can be someone if you crawl with me (3) you can be someone if you crawl with me (4)
you can be someone if you crawl with me (4) "Fishing in the Summer" 186-0170
"Fishing in the Summer" 186-0170 #119 afternoon studio floor
#119 afternoon studio floor 072-2747
072-2747 5 Colour Process- Looking Down
5 Colour Process- Looking Down A Friend in the Yard
A Friend in the Yard A Gallon
A Gallon A Gallon (Red)
A Gallon (Red) A Hockey Rink that Siassie, Bob , Fred, Tuktu Made
A Hockey Rink that Siassie, Bob , Fred, Tuktu Made A Map of the Stars (The North Pole)
A Map of the Stars (The North Pole) A Map of the Stars (The South Pole)
A Map of the Stars (The South Pole) A New Born
A New Born A Piece of Glass/ Sideglances/ Glad I Remembered to Smile
A Piece of Glass/ Sideglances/ Glad I Remembered to Smile A Time Capsule, A True Abode 1
A Time Capsule, A True Abode 1 A to Zzzz
A to Zzzz AR-Wave #86
AR-Wave #86 Aerial View of Camp
Aerial View of Camp Agape/ Agape
Agape/ Agape All Signs Point Away from Center
All Signs Point Away from Center An Arborist
An Arborist Apologue II: The Birds of Paradise
Apologue II: The Birds of Paradise Approval by the Comics Code Authority
Approval by the Comics Code Authority Aqiattulaulavik
Aqiattulaulavik Arm and Yellow Disc
Arm and Yellow Disc Art Deco Taotie
Art Deco Taotie Arthur’s House
Arthur’s House Ascension
Ascension Astral Plane
Astral Plane At the Cabin
At the Cabin Barcodes
Barcodes Basket #5
Basket #5 Basket #8
Basket #8 Beaded Amauti
Beaded Amauti Bee
Bee Bee (Blue Black)
Bee (Blue Black) Bee (Orange Cream Double Kiss)
Bee (Orange Cream Double Kiss) Bee (Yellow Lavender Gloss)
Bee (Yellow Lavender Gloss) Bent Lines
Bent Lines Between '17 and '18
Between '17 and '18 Between '17 and '18
Between '17 and '18 Blue Movement
Blue Movement Bokeh Mirror (Full length)
Bokeh Mirror (Full length) Bouquet (small colour 1)
Bouquet (small colour 1) Bouquet for Acapulco
Bouquet for Acapulco Breathe
Breathe Broken Ceramics and Wood on Blue (Abundance, Archaeology, Desire, Distribution, Economy, Excess, Failure, Frustration, History, Isolation, Longevity, Luxury, Memory, Precarity, Production, Success, Uncertainty)
Broken Ceramics and Wood on Blue (Abundance, Archaeology, Desire, Distribution, Economy, Excess, Failure, Frustration, History, Isolation, Longevity, Luxury, Memory, Precarity, Production, Success, Uncertainty) Buddha Taking a Selfie
Buddha Taking a Selfie Butler's Pantry
Butler's Pantry Casual system
Casual system Cells and Tissues
Cells and Tissues Ceramic Bowl with Papaya and Clementines on Blue with Middle Grey (Abundance, Anxiety, Balance, Citrus Collapes, Digestion, Distribution, History, Isolation, Meditation, Precarity, Saturation, Storage, Uncertainty)
Ceramic Bowl with Papaya and Clementines on Blue with Middle Grey (Abundance, Anxiety, Balance, Citrus Collapes, Digestion, Distribution, History, Isolation, Meditation, Precarity, Saturation, Storage, Uncertainty) Cheek by Jowl (Constellation 1)
Cheek by Jowl (Constellation 1) Chiromancie #12 Goma No. 2
Chiromancie #12 Goma No. 2 Chiromancie #14 n°9
Chiromancie #14 n°9 Clear Eyes Full Heart
Clear Eyes Full Heart Cobblestone Garden #1 (After Arthur Erickson)
Cobblestone Garden #1 (After Arthur Erickson) Cobblestone Garden #4 (After Arthur Erickson)
Cobblestone Garden #4 (After Arthur Erickson) Composition
Composition Composition (Building A House)
Composition (Building A House) Composition (Coloured Pencils)
Composition (Coloured Pencils) Composition (Kinngait Hotel)
Composition (Kinngait Hotel) Composition (Quilt Pattern)
Composition (Quilt Pattern) Composition (Shipper Skippers)
Composition (Shipper Skippers) Composition 2: Mother of Salt Water
Composition 2: Mother of Salt Water Composition 2: Waiting Inside a Rock
Composition 2: Waiting Inside a Rock Convalescent Swallow
Convalescent Swallow Coulis
Coulis Cross
Cross Crossed Guitars
Crossed Guitars Crusher (Rust)
Crusher (Rust) Crusher (Yellow Ochre)
Crusher (Yellow Ochre) DS
DS Daisy
Daisy Done Deal
Done Deal Double Fake Double Morisseau
Double Fake Double Morisseau Drawing on the Floor
Drawing on the Floor Droplets Lemon Sprout
Droplets Lemon Sprout Dryland Farming #24, Monegros County, Aragon, Spain 2010
Dryland Farming #24, Monegros County, Aragon, Spain 2010 Du Printemps
Du Printemps Dublin 1
Dublin 1 Einstein
Einstein Elegy for Alex Wildstar
Elegy for Alex Wildstar Elizabeth the Second, The Gazette Tuesday, June 2, 1953
Elizabeth the Second, The Gazette Tuesday, June 2, 1953 Embrasure
Embrasure Embroidered Monochrome Propositions: O series
Embroidered Monochrome Propositions: O series Embroidered Monochrome Propositions: O series
Embroidered Monochrome Propositions: O series Emergency in Waiting (Gold)
Emergency in Waiting (Gold) En Text 1-5 (should-change-old-pre-end)
En Text 1-5 (should-change-old-pre-end) Endless Spring VII
Endless Spring VII Entrevoir le jour _ Horizon 7
Entrevoir le jour _ Horizon 7 Escape to Paradise
Escape to Paradise Eye-beam
Eye-beam Farnsworth Sampler
Farnsworth Sampler Faux Monuments Object #3
Faux Monuments Object #3 Fill
Fill First Flight
First Flight Flottes 9
Flottes 9 Flowers
Flowers Flowers #2 (Changing Whites)
Flowers #2 (Changing Whites) Flowers #2 (Lavender Yellow Gloss)
Flowers #2 (Lavender Yellow Gloss) Flowers #2 (Orange Cream)
Flowers #2 (Orange Cream) Flowers (double kiss)
Flowers (double kiss) Flowers (peach and green)
Flowers (peach and green) Forever in the Sky (Mission, San Francisco)
Forever in the Sky (Mission, San Francisco) Frame #2 (Med)
Frame #2 (Med) Framing Potential
Framing Potential Frost
Frost GTO Racer X I Love My Car Go-Boy
GTO Racer X I Love My Car Go-Boy Ghost Fragment B52 (Freer Study Collection)
Ghost Fragment B52 (Freer Study Collection) Gloucester Composite
Gloucester Composite Gut Jacket II
Gut Jacket II Gut Jacket III
Gut Jacket III Géométrie variable, 6-1
Géométrie variable, 6-1 Géométrie variable, 6-2
Géométrie variable, 6-2 Hanging by a thread. Numero 6
Hanging by a thread. Numero 6 Hautes herbes
Hautes herbes Hose with Yellow Stand on Burnt Sienna (Ambiguity, Archaeology, Balance, Culture, Digital, Economy, Modern, Production, Translation, Unnecessary)
Hose with Yellow Stand on Burnt Sienna (Ambiguity, Archaeology, Balance, Culture, Digital, Economy, Modern, Production, Translation, Unnecessary) Hot House
Hot House House with Scaffolding, Seyðisfjörður
House with Scaffolding, Seyðisfjörður House, Seyðisfjörður
House, Seyðisfjörður Hurry Hard
Hurry Hard I Like!
I Like! I Reinforced with such determined frequency that I would dissonate
I Reinforced with such determined frequency that I would dissonate In Absentia (Ultramarine Blue - White)
In Absentia (Ultramarine Blue - White) In Search of Beluga
In Search of Beluga Inside the Mountain
Inside the Mountain Inside the Mountain
Inside the Mountain Intercom
Intercom Inuvik's Fox Tail Flowers
Inuvik's Fox Tail Flowers Jasper, Elizabeth, Wilfrid, Zeiss, William
Jasper, Elizabeth, Wilfrid, Zeiss, William K-PG
K-PG Kimono Target: Omotesando
Kimono Target: Omotesando La Guardia
La Guardia Ladies in Beaded Amautiq
Ladies in Beaded Amautiq Laptop with Ukulele
Laptop with Ukulele Laundry
Laundry Le Buckminsterfullerene!
Le Buckminsterfullerene! Les belle surprises
Les belle surprises Les couleurs de Cezanne dans les mots des Rilke 4/ 100-Essai
Les couleurs de Cezanne dans les mots des Rilke 4/ 100-Essai Lisa lives on that Island
Lisa lives on that Island Lombardo House
Lombardo House Lonely Couple
Lonely Couple Magnetic Separation (Graphite)
Magnetic Separation (Graphite) Mamie Till
Mamie Till Maritime
Maritime Mass
Mass Meditation
Meditation Menzel's Foot
Menzel's Foot Mesoderm (Yellow Sprouts)
Mesoderm (Yellow Sprouts) Microbes Swabbed from a Pallet Used by A.J. Casson
Microbes Swabbed from a Pallet Used by A.J. Casson Microbes Swabbed from a Pallet Used by Frederick Varley
Microbes Swabbed from a Pallet Used by Frederick Varley Microbes Swabbed from a Pallet Used by Tom Thomson
Microbes Swabbed from a Pallet Used by Tom Thomson Mirror (Paris) #2
Mirror (Paris) #2 Moi au Louvre
Moi au Louvre Mon Hiver Chez Toi
Mon Hiver Chez Toi Mother
Mother Mountain Grove Gathering
Mountain Grove Gathering Mountainside
Mountainside Mountainside
Mountainside Mud Wrestle
Mud Wrestle Multicolour Crochet
Multicolour Crochet Munari's Eyes
Munari's Eyes My Dream Gold Pin
My Dream Gold Pin My Trip to Europe
My Trip to Europe New Line of Gravity #4
New Line of Gravity #4 New Line of Gravity #5
New Line of Gravity #5 New Line of Gravity #6
New Line of Gravity #6 New Line of Gravity #7
New Line of Gravity #7 Night Eye
Night Eye No. 20
No. 20 Nope
Nope Northern River 5 Camera Crane
Northern River 5 Camera Crane Nourish
Nourish Oasis
Oasis Oil Bunkering #2, Niger Delta, Nigeria, 2016
Oil Bunkering #2, Niger Delta, Nigeria, 2016 On the Warpath: Issue #7
On the Warpath: Issue #7 One Line has Two Shapes- No.1
One Line has Two Shapes- No.1 One Line has Two Shapes- No.2
One Line has Two Shapes- No.2 One Time or Another
One Time or Another Opera
Opera Orange Acoustic
Orange Acoustic Orbits (zen)
Orbits (zen) Osyter Catcher
Osyter Catcher Par dessus/ dessous #9
Par dessus/ dessous #9 Paradise
Paradise Pick Cherry
Pick Cherry Picture 5, Toronto (Panel 1)
Picture 5, Toronto (Panel 1) Picture 5, Toronto (Panel 2)
Picture 5, Toronto (Panel 2) Pink Coat and Rhododendrons
Pink Coat and Rhododendrons Portrait of Malaika I
Portrait of Malaika I Pretty Machine 2
Pretty Machine 2 Raisin River
Raisin River Rationalizing Solitary Efforts to Substantiate Fiction
Rationalizing Solitary Efforts to Substantiate Fiction Rebirth of Chill
Rebirth of Chill Red Clover (Trifolium) Blue
Red Clover (Trifolium) Blue Red Foxgloves with Thorns (Neoliberalism)
Red Foxgloves with Thorns (Neoliberalism) Rework
Rework Ritualized Comfort without Historical Authority
Ritualized Comfort without Historical Authority Rudy the Rabbit
Rudy the Rabbit Rudy the Rabbit (Orange and Teal)
Rudy the Rabbit (Orange and Teal) Rudy the Rabbit (Red and Blue)
Rudy the Rabbit (Red and Blue) Rustic Hero
Rustic Hero Salt Ponds #4, Near Naglou Sam Sam, Senegal, 2019
Salt Ponds #4, Near Naglou Sam Sam, Senegal, 2019 San Titre (Spencer Finch)
San Titre (Spencer Finch) San Titre (flux 2019.02.23)
San Titre (flux 2019.02.23) San Titre (flux 2019.05.21)
San Titre (flux 2019.05.21) Sarrasine (Balzac)
Sarrasine (Balzac) Sea wall
Sea wall Seeing Studies: Trellis
Seeing Studies: Trellis Self-Portrait with Lemon Heart
Self-Portrait with Lemon Heart Semiotics Aside (Landscape 020)
Semiotics Aside (Landscape 020) Seraph
Seraph Shila the Great
Shila the Great Silent Trans-Forming
Silent Trans-Forming Single Mother of Three Boys
Single Mother of Three Boys Sketch 2 (stairwell)
Sketch 2 (stairwell) Slave Lake
Slave Lake Snowblob #1
Snowblob #1 Soie verte
Soie verte Solid Plans (Petrified Wood)
Solid Plans (Petrified Wood) Spine
Spine Star Value Maps
Star Value Maps Storage
Storage Strawberry Letter
Strawberry Letter Structural Trap (Salt)
Structural Trap (Salt) Studio Portrait (Man Playing Chess)
Studio Portrait (Man Playing Chess) Study for a Landscape #1, #2, #3, #4, #5, #6, #7, #8
Study for a Landscape #1, #2, #3, #4, #5, #6, #7, #8 Study of Two Fish
Study of Two Fish Sunset Worm I
Sunset Worm I Sunset Worm II
Sunset Worm II Sword of the Sun
Sword of the Sun Synapse (38-01)
Synapse (38-01) Takeout (Coffee)
Takeout (Coffee) Tattooed Faces
Tattooed Faces Terra Portfiolio D
Terra Portfiolio D Terra Portfolio A
Terra Portfolio A Terra Portfolio B
Terra Portfolio B Terra Portfolio C
Terra Portfolio C Terra Portfolio E
Terra Portfolio E The Archer 11
The Archer 11 The Bend
The Bend The Club
The Club The Difference Between
The Difference Between The Fabric. The Anger. The River. 02
The Fabric. The Anger. The River. 02 The Guy with the Eyes
The Guy with the Eyes The Park (Pale Peach)
The Park (Pale Peach) The Park (Yellow Lavender Gloss)
The Park (Yellow Lavender Gloss) The Place I would like to be with you
The Place I would like to be with you The Senses, for Colour Blindness
The Senses, for Colour Blindness The Sound of a Rainbow, Colour Ripple
The Sound of a Rainbow, Colour Ripple The Threads that Connect Us
The Threads that Connect Us The Three
The Three The Three Sisters
The Three Sisters The Tower
The Tower Thirteen Pouches for Thirteen Songs
Thirteen Pouches for Thirteen Songs Three Inuit are camping near the East side of Baker Lake to camp for the summer in July
Three Inuit are camping near the East side of Baker Lake to camp for the summer in July Threshhold, 11 Ossington Avenue
Threshhold, 11 Ossington Avenue Threshold, 11 Garnet Avenue
Threshold, 11 Garnet Avenue Threshold, 2 Concord Avenue
Threshold, 2 Concord Avenue Tidal Structure
Tidal Structure Token (Monkey Jar)
Token (Monkey Jar) Tree ( Lavender Yellow)
Tree ( Lavender Yellow) Tree (Lavender Cream)
Tree (Lavender Cream) Tree (Lavender Pale Blue)
Tree (Lavender Pale Blue) Tree (Lavender Pink)
Tree (Lavender Pink) Tree (Yellow Lavender Double Kiss)
Tree (Yellow Lavender Double Kiss) Tree (green and pink)
Tree (green and pink) Tree (peach and green)
Tree (peach and green) Trellis
Trellis Trembling Lake
Trembling Lake Two Inuit are walking Through The Mountains and one are carrying caribou on there back in June
Two Inuit are walking Through The Mountains and one are carrying caribou on there back in June Two Quinnquliks
Two Quinnquliks Two Reds and a Blue
Two Reds and a Blue Uncategory 14 Land
Uncategory 14 Land Unfurling Limb
Unfurling Limb Untitiled 05
Untitiled 05 Untitled
Untitled Untitled
Untitled Untitled
Untitled Untitled
Untitled Untitled
Untitled Untitled
Untitled Untitled
Untitled Untitled
Untitled Untitled
Untitled Untitled (Black and White #2)
Untitled (Black and White #2) Untitled (Blancs D'Ombres i)
Untitled (Blancs D'Ombres i) Untitled (Sanderling)
Untitled (Sanderling) Untitled (Spring Breakup)
Untitled (Spring Breakup) Untitled (Vine of Globes)
Untitled (Vine of Globes) Untitled (composition)
Untitled (composition) Untitled (tent)
Untitled (tent) Untitled (tent)
Untitled (tent) Untltled (composition)
Untltled (composition) Utopia #2
Utopia #2 Waabigwan Composition (study)
Waabigwan Composition (study) Water Rises Above (Anìwibi)
Water Rises Above (Anìwibi) Watermelon
Watermelon We Root Up with the Stars
We Root Up with the Stars Whale Hunting
Whale Hunting Whalebone Compostion I
Whalebone Compostion I Whalebone Compostion II
Whalebone Compostion II White Castle
White Castle Winter Flower
Winter Flower Winter Sleight Ride (Maud Lewis/ Canada Post)
Winter Sleight Ride (Maud Lewis/ Canada Post) Winterlude
Winterlude Wood 1
Wood 1 Wood 3
Wood 3 Wrapped
Wrapped Wrapped Monochrome
Wrapped Monochrome Yes, OK, Soul Power
Yes, OK, Soul Power You Be Me
You Be Me Zusatzblatt
Zusatzblatt press++30.47
press++30.47 untitled (emerging figure)
untitled (emerging figure) you can be someone if you crawl with me (1)
you can be someone if you crawl with me (1) you can be someone if you crawl with me (2)
you can be someone if you crawl with me (2) you can be someone if you crawl with me (3)
you can be someone if you crawl with me (3) you can be someone if you crawl with me (4)
you can be someone if you crawl with me (4)